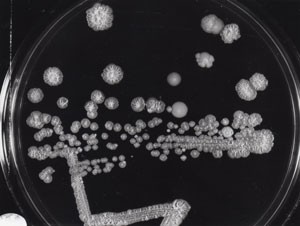

Chromosome Instability & Drug Resistance
Candida albicans
Candida albicans is a unicellular budding fungus that forms part of normal gut or genitalia microflora. In immunocompromized humans, however, C. albicans becomes an important opportunistic pathogen that can cause mortality. C. albicans is unique among other fungal pathogens by having an ability to infect divers sites of human body, including skin, nails, mucosal surfaces, as well as any other tissues or inner organs. In the laboratory, this fungus demonstrates an impressive ability to flourish under extreme pH and temperatures, as well as in other extreme environments. C. albicans possesses an acute ability to counter act the environmental stresses and to mount adequate phenotypic responses.
Since 1935, scientists reported spontaneously occurring colonies of C. albicans that derived from regular smooth colonies and had various altered colony forms, as well as multiple phenotypic changes. We demonstrated that various spontaneous chromosomal alterations are responsible for alterations of colony appearances. Importantly, we also showed that chromosomal alterations contribute to the diversity of phenotypes in population of cells, including utilization of nutrients.
We made the remarkable discovery that C. albicans evolved an unusual mechanism of survival in adverse environments that cause lethality or inhibit growth. This naturally diploid microbe adapts to a specific environment by losing or gaining an entire specific chromosome or a large portion of a specific chromosome. For example, survival on the medium containing the antifungal drug caspofungin or the toxic sugar L-sorbose, which kills C. albicans in a fashion similar to caspofungin, involves the loss of one copy of chromosome 5 (Ch5).

Elena Rustchenko-Bulgac, Ph.D.
Principal Investigator
Affiliations
- Echinocandin Adaptation in Candida albicans Is Accompanied by Altered Chromatin Accessibility at Gene Promoters and by Cell Wall Remodeling.; Journal of fungi (Basel, Switzerland); Vol 11(2). 2025 Feb 01.
- Candida albicans Genes Modulating Echinocandin Susceptibility of Caspofungin-Adapted Mutants Are Constitutively Expressed in Clinical Isolates with Intermediate or Full Resistance to Echinocandins.; Journal of fungi (Basel, Switzerland); Vol 10(3). 2024 Mar 19.
- Genome-Wide DNA Changes Acquired by Candida albicans Caspofungin-Adapted Mutants.; Microorganisms; Vol 11(8). 2023 Jul 25.
Contact Us
Rustchenko-Bulgac Lab
MC 3-8553
601 Elmwood Ave
Rochester, NY 14642
(585) 271-2683

